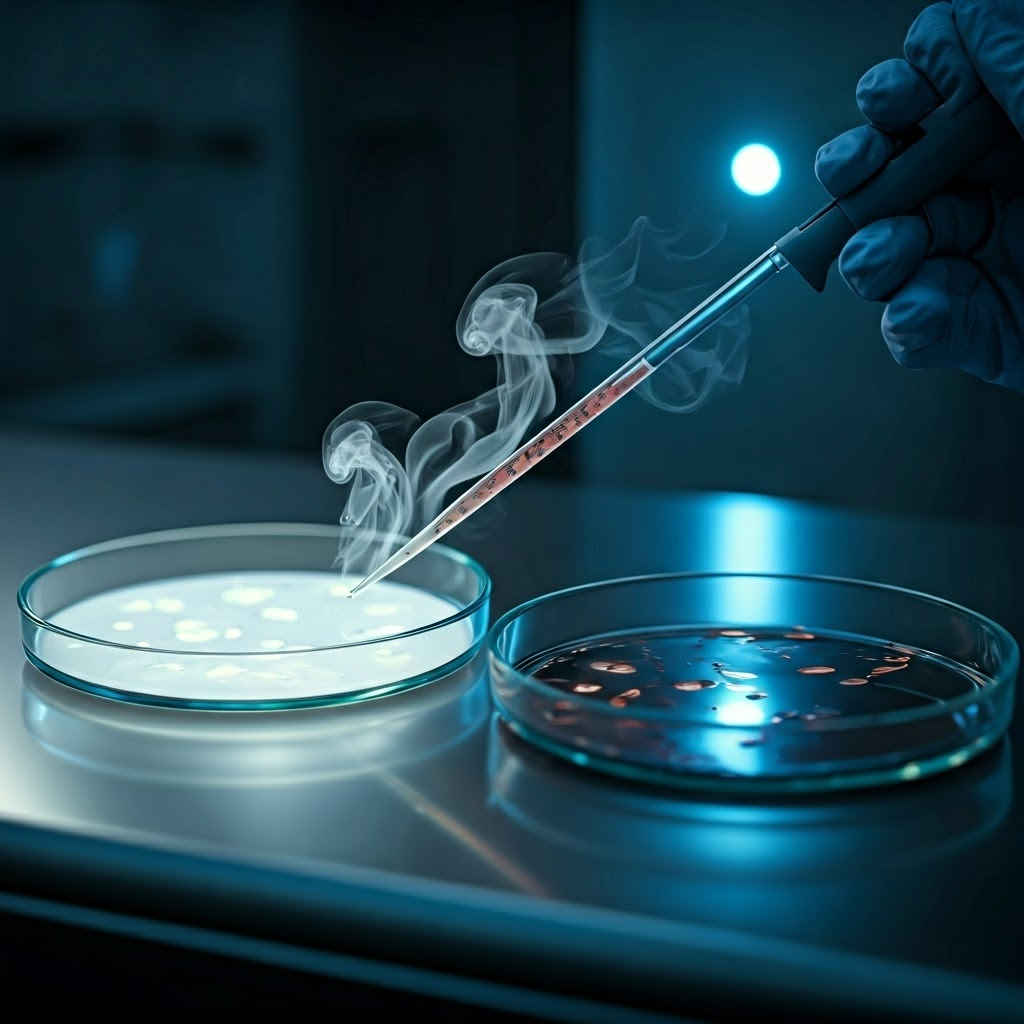
Two Petri dishes: one harmless, one turning dangerous as wisps of DNA drift between them under blue lab lights.

From Peas to Patterns: The First Clues

Mendel’s Peas and the Puzzle of Inheritance
Imagine Gregor Mendel, a calm Austrian monk in the 1800s, standing among neat rows of pea plants. He tracks how each visible trait—purple or white flowers, tall or short stems—moves between generations.
Mendel selects plants with clear differences. Each season, he cross-breeds chosen pairs and notes every result. His garden becomes a living notebook of cause and effect.
He sees patterns instead of blends. Purple flowers dominate at first, yet white flowers return later. The ratio settles near three purple to one white in the second generation.
Mendel concludes that invisible units, later called genes, guide each trait. One unit comes from each parent, giving precise instructions for growth.
He records numbers, does simple math, and confirms a repeatable code of inheritance. Though his peers overlook the work for decades, his ratios quietly set the rules of genetics.

The Search for the Secret Ingredient
By the early 1900s scientists ask what these instructions are made of. Most bet on complex proteins; DNA seems too simple with only four repeating letters.
In the 1940s Oswald Avery, Colin MacLeod, and Maclyn McCarty run a transformation test with bacteria. Harmless strains turn deadly after contact with material from dead virulent cells.
They remove proteins, fats, and sugars—transformation still happens. When they destroy DNA, the change stops. The evidence points to DNA as the real carrier of genetic information.
Skeptics struggle with DNA’s plain structure, yet repeated results force acceptance. Textbooks later mark this moment as DNA’s rise to center stage.
Patterns in the Lab: Setting the Stage for DNA
After Mendel and Avery, inheritance looks orderly, not random. A physical code must sit inside every cell.
Scientists now ask how DNA stores instructions. Knowing the molecule exists is like holding a closed book—you trust words lie inside but cannot yet read them.
Researchers compare DNA from plants, animals, and microbes. Everywhere they find the same four letters—A, T, C, G. Variety seems to arise from their arrangement, not from exotic protein mixes.

Curiosity spreads through labs worldwide. Teams break down DNA, map its parts, and search for structural clues that could explain its elegance.
Think of it this way: Mendel reveals the pattern, Avery provides the material, and together they launch the quest to decode life’s instructions.

